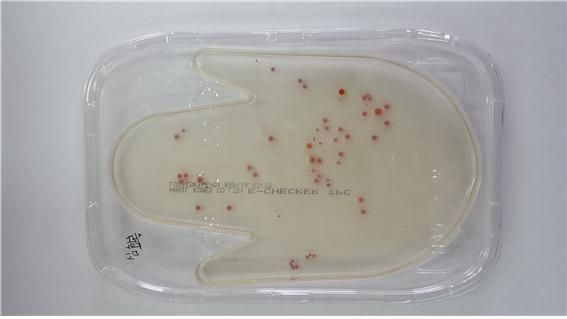

경상남도 보건환경연구원은 초등학교 4학년이상 중학생을 대상으로 청소년 보건·환경 과학체험교실을 운영한다고 밝혔다. 연중 월 1회 실시되며, 방학기간 동안에는 월 2회 실시된다. 수업 과정은 미생물, 식품, 안전성교실 및 환경교실 4개 과정이다.
체험과학교실은 일선 학교의 과학교육에서 접하지 못한 첨단 분석장비를 이용해 내 손안의 세균수 측정, 현미경으로 모기 및 진드기 관찰, 식품 중 타르색소 분석, 용액의 pH측정, 실험기구 다루기, 생활용품 중 형광증백제 찾아보기, 식품의 방사능검사 따라하기, 물벼룩을 이용한 환경 생태독성 관찰하기, 소음도 측정 등을 체험한다.
경남 보건환경연구원 관계자는 "수업은 각 분야의 전문가와 함께 이론을 바탕으로 한 실험으로 알기 쉽고 재미있게 운영되며, 평소 학교에서는 접해보지 못한 과학 분야를 체험과 학습을 통하여 호기심을 유발하고 과학의 원리가 실생활에 미치는 영향과 그 중요성을 알아가는 시간이 될 것이다"고 말했다.
교육인원은 회당 20명 내외를 선착순으로 모집하고 참가비는 무료다. 자세한 내용은 보건환경연구원 홈페이지(http://knhe.gsnd.net) 참여마당의 과학체험교실을 통하여 확인 가능하며, 신청은 전화(☎ 055-254-2256) 또는 홈페이지로 하면 된다.
![]() |
| 내 손안에 세균 측정 실험/ 자료제공=경남 보건환견연구원 |